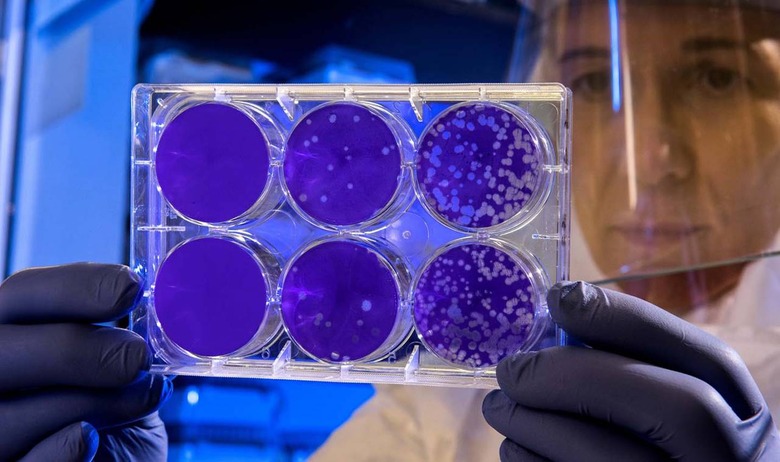

Coronavirus Fears In US Are Focusing On The Wrong Thing
The public is carefully watching the ongoing coronavirus outbreak in China and for good reason. However, many have become distracted by this particular virus, raising concerns over an infectious disease that pales in comparison to other, more deadly viruses already active in their own countries. For people living in the United States, the seasonal influenza virus, not the coronavirus, should be getting the most attention.READ: Coronavirus symptoms, 2019-nCoV virus in China, case map, and CDC help
As of the end of January 2020, coronavirus was reported to have claimed 170 lives in China. In comparison, the Centers for Disease Control and Prevention reports on its website that the seasonal influenza virus has claimed an estimated 10,000 to 25,000 lives in the United States from October 1 through January 25.
More than 180,000 people have been hospitalized due to the flu and there have been an estimated 19 million to 26 million flu illnesses over the last few months. This is substantially more than the reported number of 2019-nCoV outbreak cases and deaths despite the Wuhan virus having been active for around the same period of time as the seasonal flu virus.

As of the week of January 25, 2020, the CDC reported that flu virus activity is very high in nearly every state, with only Ohio, Michigan, and Nevada reporting low-to-moderate activity and a handful of states reporting moderate-to-high activity levels. Weekly maps of flu activity across the United States can be found on the CDC's website here.
The CDC is working with airports to screen passengers inbound from areas with active coronavirus — as well, some people who have returned to the US from China have been quarantined as a precautionary measure. This effort has greatly curbed the presence of 2019-nCoV in the United States and barring some unexpected change or mutation in the virus, officials say it is unlikely the US will experience any sort of significant outbreak related to this virus.
However, the seasonal flu remains a big public health concern and in addition to getting vaccinated, the CDC is urging everyone in the nation to exercise proper hygiene and take preventative steps to avoid acquiring and spreading the flu virus. These efforts include proper and frequent handwashing, staying home if sick with the virus, covering your mouth when coughing or sneezing, and more.